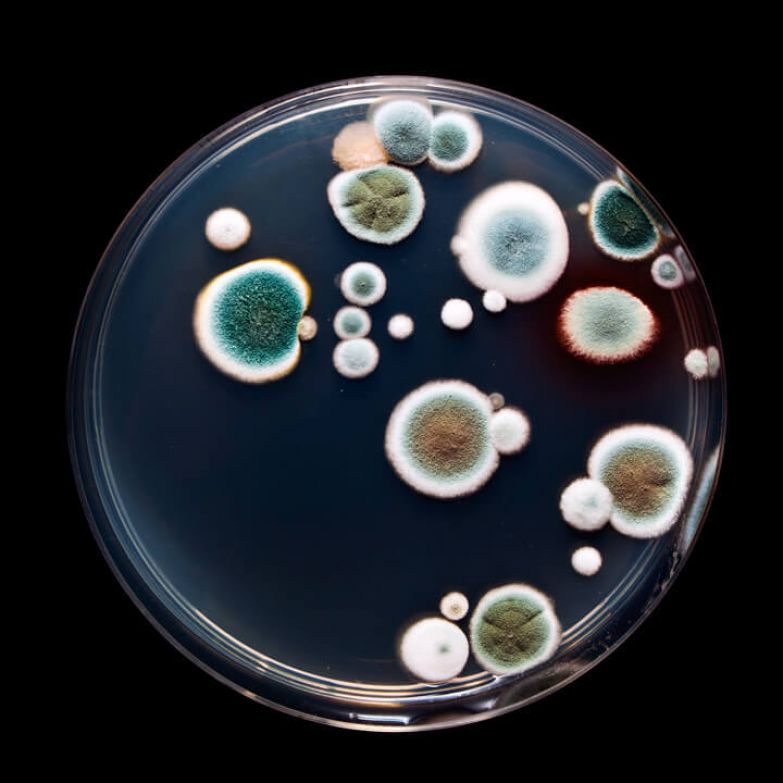
Тревожные признаки наличия грибков в организме: Что делать

Сегодня - необычная тема. Статья для тех, кого не остановить на пути к здоровью 😄 Пополним копилку восточных премудростей?
Вы знаете, как я люблю восточные техники оздоровления и очень скептически отношусь к западным, которые направлены в основном на устранение симптомов и больше подходят для экстренных ситуаций, когда требуется уже очень серьезное и капитальное вмешательство в организм.
Изящно о сложном. Фото из открытого доступа
Представим, что речь сейчас о людях относительно здоровых. Почему именно "относительно"? Потому что абсолютно здоровых в наше время, пожалуй, практически не встретишь. А хотелось бы. Это - главная причина, по которой я веду свой канал с 2018 года. И сегодня предлагаю статью о том, как сохранить здоровье по одной из древнейших традиционных систем - Аюрведе.
Конечно, я - не специалист, поэтому пользуюсь только самыми простыми и общедоступными приемами. Но буду рада, если они вам тоже пригодятся и понравятся.
❗ Внимание! Статья ни при каких обстоятельствах не является руководством к самодиагностике и самолечению. Могут быть противопоказания, причем серьезные. Консультируйтесь со специалистом!
3 уровня недуга
Современная западная медицина направлена на то, чтобы заниматься болезнью на физическом уровне: убрать боль, отсечь патологическое.
Восточная медицина, включая Аюрведу и ТКМ (традиционную китайскую медицину), рассматривает любой недуг как минимум на 3 уровнях:
1. Сознание. Заболевание сначала появляется именно здесь. Грубо говоря, в наших мыслях, настрое, убеждениях. Все начинается на ментальном уровне. Но не в избитом значении, мол, "мысли материальны". Если бы это было так, то, например, голодающие дети получили бы вожделенный кусок лепешки. Речь идет именно о настрое: озлобленность, обида, гнев, уныние, осуждение - далеко не полный перечень состояний, с которых организм начинает разрушаться.
Все начинается на ментальном уровне. Фото из открытого доступа
2. Энергетическое тело. На этом этапе появляются неочевидные признаки, на которые редко обращают внимание. Либо списывают на банальную усталость. Например, когда накатывает чувство отчаяния и бессилия, апатия и нежелание чем-то заниматься - это предвестники психического недуга (депрессия, агрессия и т.д.) или физического (об этом - далее).
3. Физическое тело. Это - те симптомы, которые уже очевидны: боль, изменение цвета кожи и иные видимые проявления. Обычно только на таком этапе человек и начинает судорожно лечить симптомы, обращается к врачу.
Иногда ошибочно называют заботой о своем здоровье именно те действия, которые предпринимают на последнем уровне. Но таблеточки, любовно разложенные по часам приема, это уже крайняя мера. Хорошо еще, если человек берется за себя хотя бы на втором уровне, когда недуг проявляет себя в перепадах настроения, бессоннице, раздражительности и ощущении бессилия. Но гораздо лучше, если позаботиться о себе на самой первой ступени - уровне сознания. И тогда до последней дело не дойдет. Попробуем?
4 уровня здоровья
Согласно Аюрведе мы можем достичь 4 уровней здоровья:
1️⃣ Арогья. Это - низший уровень. И большинство людей стремятся хотя бы к нему. "Арогья" переводится как "отсутствие страданий физического тела". То есть мы не чувствуем нигде боли, все системы организма работают полноценно. На самом деле это уже отличный результат по нынешним меркам.
2️⃣ Сукхам. В переводе с санскрита означает "мирское счастье". Это - удовлетворенность на уровне материального мира. Когда у вас достаточно хорошие взаимоотношения со всеми людьми в целом, устраивает работа, есть деньги на необходимое, а также есть понимание собственного предназначения в жизни. Для многих людей такой уровень - предел мечтаний. В Японии его называют "икигаем". В нашу эпоху это действительно очень высокий результат, которого достигает только малый процент людей.
На этом уровне уже можно чувствовать себя счастливым ежедневно. И, конечно, в таком гармоничном состоянии болезни на уровне физического тела проявляются крайне редко.
Кусочек моего мирского счастья. Фото из личного архива
Здесь мы могли бы остановиться, потому что в рамках концепции моего канала этого уже достаточно. Но для самых любознательных я коротко скажу и о двух следующих уровнях.
3️⃣ Свастха. В переводе с санскрита - "укорененность в себе самом". На этом уровне человек осознает, что он не ограничен физическим телом. Он понимает духовность своей природы и совершенствует качества души.
4️⃣ Ананда. В переводе с санскрита - "блаженство". На этом уровне человек уже не зависит ни от каких внешних условий - материальный мир перестает оказывать на него влияние. Примеры людей, которые испытывали постоянную духовную удовлетворенность, есть среди представителей любой религии. Углубляться не буду, потому что такую информацию нужно читать только при большом личном желании и после самостоятельных поисков.
***
Остановимся на первых двух уровнях, ибо они понятны любому и вполне достижимы. Выражаясь простым языком, наше здоровье основано на тесной связи систем организма с психикой и разумом. Всем этим можно и нужно управлять себе во благо.
Ключевые принципы здоровья
Аюрведа как кладезь ценных знаний существует уже более 5000 лет. И нельзя сказать, что эта древняя наука устарела. Конечно, в одной статье не отобразить всю пользу и разнообразие рекомендаций, но попробую поделиться самыми простыми.
1. Гармония в питании
Полезные сезонные ягодки. Фото из личного архива
Нет, речь сейчас пойдет не о калориях. Важно учитывать несколько основных правил:
✅ Питаться в соответствии со своей конституцией. В Аюрведе они называются дошами. Их всего три. Классификация основана на 5 основных первоэлементах в природе: воде, земле, огне, воздухе и эфире.
Конституция "Вата". Это - худощавые люди: тонкие кости, хрупкие ногти, сухая кожа, вьющиеся волосы. Такие создания беспокойны, тревожны, легки на подъем, импульсивны, нередко страдают бессонницей, быстро устают. Часто бывают очень творческими и коммуникабельными. Вечно спешат, все делают быстро. Согласно Аюрведе в теле "вата" много воздуха и эфира.
Когда у вата-типа все сбалансировано, то он жизнерадостен и проявляет огромный творческий потенциал. А вот если наблюдается дисбаланс, то преобладает страх и тревожность.
Конституция "Питта". Это - люди с нормальным телосложением. Могут быстро набрать вес, но так же легко его и сбрасывают. Обычно отличаются ярким темпераментом, энергичностью, наделены качествами лидера. Целеустремленные, вспыльчивые. Согласно Аюрведе в теле "питта" много огня и воды.
Когда у питта-типа все сбалансировано, человек проявляет высокие умственные способности и удовлетворенность жизнью. А если наоборот, то развивается озлобленность, появляются язвы.
Конституция "Капха". Это - люди плотного телосложения, с тенденцией к лишнему весу. Обычно отличаются добрым нравом, любвеобильны, сострадательны. Подчас ленивы, неторопливы. Согласно Аюрведе в теле "капха" много земли и воды.
Когда у капха-типа все сбалансировано, он очень любящий и уравновешенный. А если наоборот, то проявляется зависть и беззащитность.
Доши. Фото из открытого доступа
Как определить свою дошу? Чистый тип встречается очень редко. Обычно в каждом человеке смешаны две, а то и три доши. Есть много онлайн-тестов, которые помогают определить дошу. Я на самом деле знаю свой типаж (преимущественно вата, но и питта в достаточном объеме). Проверила на первом попавшемся сайте (вот) и убедилась, что так и есть. Не реклама! Просто здесь за 33 вопроса можно бесплатно и без всяких регистраций получить достоверный результат.
Мои доши. Скриншот личного результата
При этом доши и их соотношение могут меняться в течение жизни. Вот почему в питании так важно учитывать только свои (!) особенности и не сравнивать себя с подругами/родственниками, которым может требоваться совершенно другой рацион и режим.
Например, "вата" должны есть не меньше 4 раз в сутки небольшими порциями, а у "питты" даже огромный объем еды сгорит мгновенно. "Капхе" можно обойтись единственным приемом пищи в середине дня и полезно поститься, в то время как для "ваты" голодание чревато усилением беспокойства и нервными расстройствами.
Или, например, "питте" полезно гасить свой чрезмерный огонь, добавляя в рацион больше кисломолочных продуктов и сладких фруктов. А вот "капхе" пойдут на благо острые блюда, которые разгонят метаболизм.
Подробнее лучше узнать у опытных специалистов по аюрведическому питанию.
✅ Разнообразие вкусов. Знали ли вы, что нашему организму в течение дня важны все 6 вкусов: соленый, сладкий, кислый, горький и вяжущий. Тогда и насыщение приходит быстрее, и все процессы в нашем теле нормализуются.
Любопытные факты. Если вы замечаете за собой лень, то снизьте употребление пищи со сладким вкусом. А если видите, что стали слишком гневливы или раздражительны, уменьшите или даже исключите полностью острую еду.
✅ Разнообразие цвета. Замечали, как повышается аппетит (да и настроение!) при взгляде на цветную фруктовую тарелку? Согласно Аюрведе пестрота оттенков еды имеет большое значение. Лучше поставить на стол несколько крохотных блюдечек с пищей разного цвета, чем одну лохань с коричневой мясной смесью.
✅ Разнообразие текстур. Аюрведа учитывает даже это. Хорошо, когда ежедневно на столе есть контраст из разных текстур: например, плотная, жидкая, твердая и хрустящая пища. Это помогает организму вырабатывать нужные для здоровья ферменты и даже повышает настроение. Допустим, густой гороховый суп с "хрумкими" кусочками сладкого перца принесет больше пользы, чем просто суп-пюре.
Вот почему роллы так хороши: радуют разнообразием и глаз, и язык. Правда, Аюрведой не поощряются. Фото из личного архива
✅ Время приема определенной пищи. Например, фрукты лучше есть в первой половине дня, потому что они связаны с энергией солнца и лучше усваиваются утром. А вот вечерняя фруктовая тарелка приводит к "подбраживанию" в организме. Также фрукты нежелательно смешивать с основным приемом пище.
Сухофрукты уже отличаются другой природой. Вот почему их можно добавлять даже в основные блюда и в соусы.
Весной полезно добавлять в рацион больше острого, вяжущего и горького вкуса. И меньше есть жирной, холодной, сладкой, кислой пищи. Тогда организму будет легче избежать сезонных простуд, отеков, аллергии, апатии.
Летом не рекомендуется есть много пряного, жареного, кислого и жирного. Потому что в природе и так много жара. В засушливый сезон полезно больше водянистой пищи.
Осенью пойдет на пользу вяжущий, горький и сладкий вкус, специи и теплая пища.
Зимой особенно хороши специи, зерновые, бобовые, теплая пища.
Последний прием пищи - не позднее, чем за 2 часа до сна. В течение дня рекомендуется питаться, руководствуясь чувством голода, а не часами. Например, если подошло время трапезы, а есть не хочется - лучше пропустить. Аналогично с водой: пить по чувству жажды. Вода до еды приводит к уменьшению веса, во время еды - без изменений веса, после еды - набор веса.
✅ Местные продукты
Сейчас нам доступно столько экзотической пищи. Но организму всегда полезнее те продукты, которые не везли издалека. Из фруктов лучше выбрать сезонные. Клубника зимой - это, конечно, вкусно и необычно, но лучше есть ее как редкое лакомство в январе, а вот сейчас (в июне-июле) - самое время.
Например, в Петербурге вот-вот поспеет черешня и смородина - сегодня я уже накрывала сеткой деревья и кустарники от вездесущих птиц. А через пару недель и вишня порадует.
Свои ягодки. Фото из личного архива
✅ Пища в благости, невежестве и страсти.
- Согласно Аюрведе есть пища благостная (она повышает иммунитет, продлевает жизнь, улучшает здоровье, дарит счастье и жизненную энергию). К такой еде относятся свежеприготовленные блюда, зрелые овощи и фрукты, продукты без признаков гнили и т.д.
- "Невежественная" пища. Она отнимает здоровье, будит в нас худшие качества характера, делает ленивыми и болезненными. Согласно Аюрведе это - разогретая еда и вообще все, что приготовлено давно. Знаете, какой показатель давности? Все, что приготовлено больше 2 часов назад... Кстати, не так давно читала о кавказцах, для которых простоявшее 3 часа блюдо уже воспринимается нездоровым.
К "нечистой" пище относится все, где есть пыль, песок, бактерии, волосы. Все забродившее, высохшее, прокисшее, заплесневевшее. А также "неживая еда": консервированная, с усилителями вкуса.
Также сюда относятся много продуктов, которые я нахожу слишком спорными для общей статьи (например, грибы, лук, чеснок, рыба). Не буду порождать ссоры в комментариях. Оставим эти нюансы для посвященных.
- "Страстная" пища. Это - все, к чему подходит определение "слишком". Например, даже чересчур горячая еда. Или сухая (те же сухарики). Слишком соленое, острое, приторное, кислое и т.д. Такая еда разгоняет в нас огонь и делает одержимыми, сердитыми, вспыльчивыми.
2. Гармония в жизни
Как я в Крыму гармонии добивалась)) Фото из личного архива
В Аюрведе пишется о том, что человек получает здоровье для выполнения в жизни своего предназначения. И может оставаться здоровым только в этом случае. К сожалению, лодырям и эгоистам такие новости не понравятся.
Вот основные принципы гармонии:
- Обязанности перед обществом (дхарма). Большое заблуждение считать, что мы никому ничего не должны - это западный лозунг, который многих сделал несчастными, загнал на кушетки к психоаналитикам и довел до депрессий. На эту тему, кстати, очень хорошо и доступно описано у моего любимого Стивена Кови. Но не буду повторяться. Лучше скажу: когда человек не выполняет свои обязанности перед обществом, то это ведет к неудовлетворенности жизнью и работой. И самое распространенное последствие - заболевания сердечно-сосудистой системы, гипертония и прочие сопутствующие недуги.
- Материальное вознаграждение (артха). Это, кстати, не только получение заслуженного заработка за свою трудовую деятельность, но и социальный статус, известность и все остальное, что дает добросовестное выполнение дхармы. Однако если человек начинает страдать жадностью, алчностью и стремится к накопительству, то получает, в частности, заболевания опорно-двигательного аппарата.
- Реализация желаний и требований (кама) с помощью артхи. Наши глаза, уши, язык, нос и кожа требуют определенных ощущений. И если мы удовлетворяем эти желания без излишеств, то помогаем здоровью. Однако если переходим границы или причиняем вред другим людям, то разрушаем не только свое тело, но и мозг. Так, например, плавание гармонично удовлетворяет потребности нашего тела и в особенности кожи. Но если мы начинаем чрезмерно нежиться в пенных ваннах, то становимся капризными, болезненными и уязвимыми к простудам.
- Духовное развитие (мокша). На этом пункте не могу долго останавливаться, ведь мой канал - светский. Тем более, для освобождения от невежества нужно сначала реализовать три предыдущих цели.
3. "Все болезни от нервов"
Как бы банально ни звучало, но все именно так. Аюрведа учит этому: проявилась болезнь - меняй поведение и привычки, избавляйся от негативных желаний. Так, например, постоянная тревога и страх приводят к заболеваниям почек, а гнев - к дисфункции печени. Бесполезно закидывать в себя таблетки, если ничего не менять в собственном поведении.
4. Лучшая терапия - то, что нас окружает
Мое прекрасное окружение. Фото из личного архива
Аюрведа рекомендует:
- Очищение. В узком и широком смысле. Например, водные процедуры, постные дни, очистительные техники (не только для тела).
- Ароматерапия. Аюрведа придает особое значение запахам. С их помощью можно улучшать физическое и психическое здоровье, избавляться от неприятных ощущений.
- Звукотерапия. Определенная музыка, звуки природы и просто тишина.
- Солнце, воздух, ветер, вода. Прогулки - наш лучший помощник для здоровья.
- Травы, масла и другие средства натуропатии (т.е. натуральных средств природного происхождения). А вот уже конкретные назначения должен делать специалист по Аюрведе.
5. Важные принципы Аюрведы
На самом деле их очень много. Но остановимся на простых и понятных для новичков:
✅ Ранний подъем. О да, тут нет никаких лазеек для "сов". В идеале рекомендуется вставать вместе с солнцем и даже до восхода. Но, пожалуй, вот здесь можно усомниться: что делать жителям Петербурга, карелам и всем, кто проживает за полярным кругом? Ведь круглосуточно не будешь спать или бодрствовать. Поэтому нужно руководствоваться разумом
и географическими особенностями региона. Но в любом случае ранний отбой и подъем - это аксиома здорового человека. А сон больше 8 часов - это погружение в гуну невежества, которая ведет к развращению, деградации, апатии, гневливости.
Жизнь с солнцем. Фото из личного архива
✅ Физическая активность. Да, никуда от этого не деться - человеку нужно шевелиться, чтобы оставаться здоровым. Лимфа движется только с помощью мышц. Но есть и хорошая новость: физическая активность - это вовсе не обязательно спортклуб или пробежки. Можно заниматься танцами, йогой, кататься на велосипеде или даже просто активно шагать на прогулке.
✅ Благожелательность. В самом широком смысле. То есть желать добра и себе, и людям, и любым живым существам. Уметь быть благодарными за все, даже за удары судьбы. Ничего не бывает в нашей жизни просто так. И "неудобные люди" даются нам для какой-то важной цели.
✅ Омовение. Этому придается особое значение. Водные процедуры очень быстро входят в привычку и потом без них не можешь чувствовать себя чистым, опрятным и... счастливым. Признаться, мне становится физически нехорошо, когда я случайно вижу, как в общественном туалете женщина выходит из кабинки и... даже не моет руки, а просто смотрится в зеркало и уходит. Помыть руки - самое простое гигиеническое действие. Дома, конечно, можно принять душ. Как минимум утром после пробуждения и вечером перед отходом ко сну. Водные процедуры универсальны: утром бодрят, вечером снимают усталость, в течение дня прогоняют дурные мысли.
✅ Забота о глазах, зубах и волосах. И речь не просто о красоте. Так, например, расчесывание волос направляет "энергию" к голове (если выражаться эзотерически, а если простым языком - улучшает кровообращение головы и очень благотворно влияет на умственную деятельность), снимает стресс, делает зрение более острым.
Здоровые зубы - это здоровый ЖКТ в первую очередь, а также надежные ворота против инфекций. Аюрведа рекомендует для здоровья зубов употреблять свежий имбирь, красный перец, чаще бывать на солнце, делать массаж десен. Также для очистки зубов используются травы с горьким вкусом: базилик, листья дуба.
Такие полезные травы! Фото из открытого доступа
Кстати, неприятный запах изо рта может говорить не только о заболеваниях зубов, но и в первую очередь об ухудшении пищеварения. Аюрведа рекомендует поддерживать агни ("желудочный огонь"), который гасят холодные напитки, мороженое и тяжелая пища. Для улучшения пищеварения рекомендуются чаи с добавлением фенхеля, тмина, кориандра.
Глаза - зеркало души, а зрение - величайший дар, который стоит беречь. Глаза относятся к очень чувствительному органу восприятия. Согласно Аюрведе самый большой враг глазам - это, конечно, не компьютер, а сильные перепады температуры. Например, если вы любите нырять с головой в прорубь после бани, то отличное зрение с трудом удастся сохранить.
Также рекомендуется защищать глаза от дыма и частых слез. Вредно для глаз и тусклое освещение, сильный ветер в лицо (особенно при поездке на современном транспорте). И, как ни странно, но проблемы со зрением возникают у тех, чьи волосы иссушаются - так говорит Аюрведа (не я). Поэтому забота о волосах, их увлажнение - это одновременно и забота о глазах.
Согласно Аюрведе зрение улучшается при созерцании зеленого цвета и восхода солнца. А если вы чувствуете усталость в глазах, то рекомендуется промыть рот холодной водой. Вот почему я объединяю в одном пункте волосы, зубы и глаза.
✅ Забота о стопах.
Здоровый пример с детства. Фото из открытого доступа
Как бы ни казалось странно, но от состояния наших ступней тоже зависит зрение. Впрочем, и здоровье всех других органов. Согласно Аюрведе даже приближение ног к огню ухудшает зрение, не говоря уже о тесной и неудобной обуви. Поэтому хождение босиком при любой возможности - огромная польза для глаз, иммунитета и здоровья в целом.
Также для стоп рекомендуется регулярный массаж, но об этом у меня уже и так есть несколько публикаций на канале.
6. Конкретные советы для разных дош (вата, питта, капха)
Если вы правильно определили свой типаж, то сможете существенно улучшить здоровье на всех уровнях.
✅ Советы для вата-типа
Рекомендуется ложиться спать в одно и то же время. В питании лучше отдавать предпочтение теплой пище, орехам, фасоли, сладким ягодам и фруктам, рису, молочным продуктам. Физическая активность - средняя. Лучше не увлекаться интенсивными и изнуряющими тренировками.
✅ Советы для питта-типа
Следует ограничить употребление острой и жареной пищи. Рекомендуется избегать длительного нахождения на солнце и перегревания. Не стоит и "гореть" на работе, хотя питта-людям это очень свойственно - такие уж трудоголики. Из фруктов и овощей лучше выбирать очень сочные, водянистые. Стоит учиться воздержанию от конфликтов, несмотря на свою пылкую натуру.
✅ Советы для капха-типа
Очень рекомендуется увеличить физическую активность, так как люди этого типажа обычно медлительны, склонны к депрессиям, набирают лишний вес. В рацион лучше добавить больше легкой пищи, не возбраняются специи. А вот жирную еду стоит исключить.
Во всем искать лучшее - это не дар, а навык. Желаю всем его обрести! Фото из открытого доступа
***
Конечно, все эти рекомендации - лишь крохотная верхушка айсберга. Ведь Аюрведа - гигантская сокровищница комплексных знаний о здоровье. Но если вы до сих пор не знали, с чего начать, то пусть эта статья станет первым шажочком на полезном пути.
Какой пункт показался вам самым интересным, а какой - самым сложным в выполнении? Мне, например, кажется недостижимым идеалом готовить пищу для семьи так, чтобы всегда ели только свежее (не более 2-3 часов с момента приготовления). Наверное, в современных реалиях это особенно трудно: приезжаешь домой в 8 вечера и не готовить же суп/второе/третье на ужин. Конечно, в выходные вполне можно трижды за сутки заниматься готовкой. А по будням я всегда делаю овощной салат к ужину и какое-то быстрое блюдо. Плюс можно выкручиваться сырыми фруктами и овощами. На мой взгляд, это и есть путь без фанатизма: по возможности стремиться к ЗОЖ, но не становиться одержимыми и помешанными на безупречности.
]]>




































 Широко распространенный по всему миру кошачий паразит, который ранее был уличен в провоцировании психических заболеваний и рискованного поведения у носителей, теперь обвиняется в истощении, потере мышечной массы и развитии слабости у пожилых людей. Авторы нового исследования из университетов Испании, Португалии и США пришли к выводу, что одноклеточный микроорганизм Toxoplasma gondii связан с синдромом старческой астении или так называемой «хрупкостью пожилых». Результаты анализа данных 601 человека опубликованы в Журнале геронтологии.
Широко распространенный по всему миру кошачий паразит, который ранее был уличен в провоцировании психических заболеваний и рискованного поведения у носителей, теперь обвиняется в истощении, потере мышечной массы и развитии слабости у пожилых людей. Авторы нового исследования из университетов Испании, Португалии и США пришли к выводу, что одноклеточный микроорганизм Toxoplasma gondii связан с синдромом старческой астении или так называемой «хрупкостью пожилых». Результаты анализа данных 601 человека опубликованы в Журнале геронтологии. Новый штамм коронавирусной инфекции «пирола» впервые зафиксировали в Великобритании 18 августа 2023 года. К концу месяца заболевших выявили в соседней Франции, позже — в США, Израиле, Португалии, Дании, ЮАР. В ноябре «пирола» добралась до России.
Новый штамм коронавирусной инфекции «пирола» впервые зафиксировали в Великобритании 18 августа 2023 года. К концу месяца заболевших выявили в соседней Франции, позже — в США, Израиле, Португалии, Дании, ЮАР. В ноябре «пирола» добралась до России.







































 Боли, спазмы, слабость и онемение мышц в области грудины – симптомы того, что продуло грудную клетку
Боли, спазмы, слабость и онемение мышц в области грудины – симптомы того, что продуло грудную клетку УЗИ – метод диагностики если продуло грудную клетку
УЗИ – метод диагностики если продуло грудную клетку Лавровое масло – народное средство если продуло грудную клетку
Лавровое масло – народное средство если продуло грудную клетку





 Симптомы отравления угарным газом
Симптомы отравления угарным газом
 Для тяжелой степени отравления характерны расширенные зрачки
Для тяжелой степени отравления характерны расширенные зрачки
 В случае, когда не прощупывается пульс, проводят непрямой массаж сердца
В случае, когда не прощупывается пульс, проводят непрямой массаж сердца
 Прибывшие на вызов медицинские специалисты вводят пациенту кислород через специальную маску
Прибывшие на вызов медицинские специалисты вводят пациенту кислород через специальную маску
 Степень отравления угарным газом невозможно определить по внешним признакам, поэтому для пострадавшего необходимо как можно скорее вызвать карету скорой помощи
Степень отравления угарным газом невозможно определить по внешним признакам, поэтому для пострадавшего необходимо как можно скорее вызвать карету скорой помощи

 С наступлением холодов каждый человек начинает готовиться к возможным заболеваниям. В ход идут витамины, теплая одежда, различные антисептики и другие способы защиты. Обычная простуда вызывает дискомфорт, но организм справляется с ней достаточно быстро. Другое дело – грипп, для эффективной борьбы с которым необходимо как можно быстрее обратиться к врачу. Почему грипп появляется именно зимой и нередко при этом превращается во вспышки, эпидемии, пандемии?
С наступлением холодов каждый человек начинает готовиться к возможным заболеваниям. В ход идут витамины, теплая одежда, различные антисептики и другие способы защиты. Обычная простуда вызывает дискомфорт, но организм справляется с ней достаточно быстро. Другое дело – грипп, для эффективной борьбы с которым необходимо как можно быстрее обратиться к врачу. Почему грипп появляется именно зимой и нередко при этом превращается во вспышки, эпидемии, пандемии?

В процессе приготовления на поверхности масла появляется пена, которую нужно убирать
В процессе приготовления на поверхности масла появляется пена, которую нужно убирать






 Чихание это защитная реакция организма. Таким образом, он избавляется от пыли или раздражающих веществ попадающих на слизистую оболочку верхних дыхательных путей. При резком форсированном выдохе, они выталкиваются наружу.
Чихание это защитная реакция организма. Таким образом, он избавляется от пыли или раздражающих веществ попадающих на слизистую оболочку верхних дыхательных путей. При резком форсированном выдохе, они выталкиваются наружу.
 Механизм чихания
Механизм чихания








 Механическая асфиксия – показание к дыханию рот в рот
Механическая асфиксия – показание к дыханию рот в рот Перед дыханием рот в рот необходимо уложить пациента спиной на твердую поверхность
Перед дыханием рот в рот необходимо уложить пациента спиной на твердую поверхность Как делается дыхание рот в рот
Как делается дыхание рот в рот













 Некоторые нейронные связи в мозге продублированы. То есть по мере отмирания одних участков их функции на себя берут другие. Одновременно с этим мозг увеличивает выработку серотонина и дофамина. Эти гормоны поддерживают эмоциональную устойчивость, повышают силу воли и снижают болевые ощущения. То есть мозг работает таким образом, чтобы предоставить организму максимально много времени для спасения жизни. В состоянии клинической смерти человек может сохранять некоторые или все виды чувств.
Некоторые нейронные связи в мозге продублированы. То есть по мере отмирания одних участков их функции на себя берут другие. Одновременно с этим мозг увеличивает выработку серотонина и дофамина. Эти гормоны поддерживают эмоциональную устойчивость, повышают силу воли и снижают болевые ощущения. То есть мозг работает таким образом, чтобы предоставить организму максимально много времени для спасения жизни. В состоянии клинической смерти человек может сохранять некоторые или все виды чувств.





































